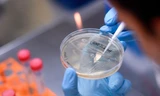
vắc xin

Trong tủ đồ của “tỷ phú hụt” Kylie Jenner có gì?
Nếu bạn tò mò thì đã có câu trả lời, vì Kylie vừa mời mọi người ghé thăm cái tủ khổng lồ của mình, cũng như cho các fan chiêm ngưỡng chiếc túi Hermès Birkin siêu đắt đỏ.
Đây có vẻ như một việc rất bình thường của các ngôi sao. Nhưng các fan của Kylie không nghĩ thế.
Lúc đầu, Kylie tiết lộ rằng, một trong những chiếc túi Birkin đầu tiên cô mua là do mẹ “xui”, với lý do là vì “nó rất hiếm”.
Sau khi trình bày xong về cái túi thần thánh, Kylie chia sẻ về những thứ mà cô cần dùng nhất: Dung dịch rửa tay, son bóng Kylie Skin, sẽ ra mắt vào tháng 10 tới.
Những món đồ mang thương hiệu của Kylie chưa dừng ở đó, mà cô còn giới thiệu thêm những món mỹ phẩm hay trang điểm, gọi chúng là “người bạn thân nhất của tôi”, “đang rất hot”… Loại “nước hoa mà lúc nào tôi cũng dùng” cũng là một sản phẩm hợp tác với Kim Kardashian.

Ngoài ra, Kylie còn “hay dùng” cả khăn lau tẩy trang, kem chống nắng, dưỡng môi, son - tất cả đều mang thương hiệu của cô.
Tuy nhiên, các fan chẳng ấn tượng với màn giới thiệu của Kylie.
Rất nhiều người tỏ ra thất vọng. Một người bình luận: “8 phút 2 giây để Kylie tự quảng cáo các sản phẩm của chính cô ta”. Một người khác viết: “Câu hỏi: “Có gì trong túi tôi?”. Câu trả lời: “Tất cả những thứ mà tôi muốn các bạn mua””.

Nhiều fan khác cho rằng, cứ tưởng Kylie sẽ chia sẻ thật lòng, nhưng dường như cô vẫn quen làm “show”, chỉ khoe khoang và tự quảng cáo.
Có người khẳng định: “Tôi rất thích Kylie nhưng tôi không bao giờ tin được mỗi khi cô ấy nói: “Đây là sản phẩm tôi yêu thích, thật đấy””.